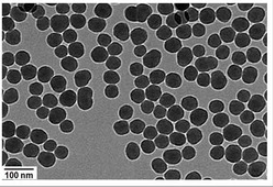

├¹ĘQŻ║╝{├ūSiO2
ĮM│╔Ż║SiO2
┴ŻÅĮŻ║~100nm
æ¬ė├Ż║Ė╬╝Ü░¹ūį╩╔╣”─▄╬╔üyĄ─ĘųūėÖCųŲ
ā”┤µŚl╝■Ż║-4Īµ
Ųõ╦¹šf├„Ż║├▄ĘŌĀŅæBŽ┬▒Ż┘|Ų┌░ļ─ĻĪŠų„ę¬ā×ä▌Ī┐╝{├ūSiO2═©▀^ROSšT░lā╚┘|ŠWæ¬╝ż��Ż¼╝ż╗ŅEIF2AK3Ż©PERKŻ®║═ATF6ą┼╠¢═©┬Ę��Ż¼╔Žš{Ž┬ė╬▐Dõøę“ūėATF4║═DDIT3Ż©CHOPŻ®���Ż¼Å─Č°┤┘▀Mūį╩╔╗∙ę“ATG12║═LC3B▐DõøŻ¼į÷ÅŖūį╩╔¾w║Ž│╔�Ż¼▀MČ°╝ėäĪūį╩╔¾wĘe└█���Ż¼ę²Ųūį╩╔╣”─▄╬╔üy�Ż¼ī”╝Ü░¹«a╔·ČŠąį����ĪŻ
Ņ}─┐Ż║
Silica nanoparticles induce autophagosome accumulation via activation of the EIF2AK3 and ATF6 UPR pathways in hepatocytes
╬─š┬µ£ĮėŻ║
https://news.ccmu.edu.cn/syyw_12977/95626.htm

┴¶čįū╔įā
┴¶čįū╔įā
|
|
 |
| ╔·╬’╝{├ū▓─┴ŽŪ░čž |
 |
| ╝{├ūßtīWFrontier |
|
£ž▄░╠ß╩ŠŻ║╠Kų▌▒▒┐Ų╝{├ū╣®æ¬«aŲĘāHė├ė┌┐Ųčą����Ż¼▓╗─▄ė├ė┌╚╦¾w,▓╗═¼┼·┤╬«aŲĘęÄĖ±ąį─▄ėą▓Ņ«ÉĪŻŠWšŠ▓┐Ęų╬─½I░Ė└²łDŲ¼į┤ūį╗ź┬ōŠWŻ¼łDŲ¼āH╣®ģó┐╝�����Ż¼šłęįīŹ╬’×ķų„�����Ż¼╚ńėąŪųÖÓšł┬ōŽĄ╬ęéā┴ó╝┤äh│²��ĪŻ
╠ß╩Ššf├„Ż║╝{├ū▓─┴Ž╣ż╦ć║═ųŲéõ┐╔─▄Ģ■ėąĖ─ūā ╦∙ėą╝{├ū▓─┴ŽŠ∙ų¦│ų░┤ąĶČ©ųŲ Ž┬å╬Ū░┬ōŽĄ┐═Ę■┤_šJ«aŲĘįö╝Üą┼ŽóĪŻ |
